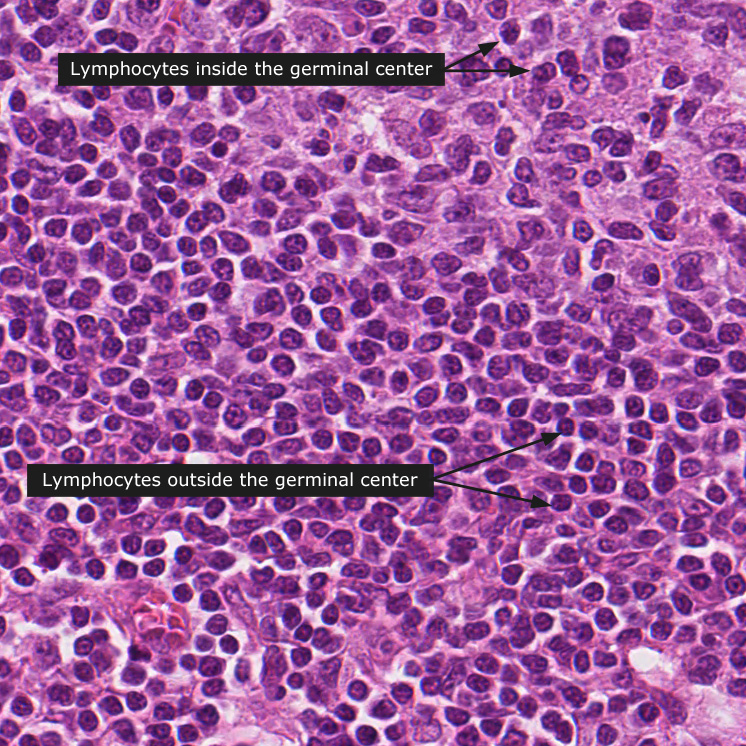

Lymph node
Lymph node
The lymphatic system forms the immunological fundament for the body's defense system. A circulating pool of lymphocytes ensures a continuous immunologic surveillance of the entire body in order to protect against harmful invasion. These cells circulate between various lymphoid tissues, and the lymph and bloodstream. When certain lymphoid cells come in contact with their determined target antigens, these cells return to the lymphatic tissue to differentiate and proliferate.
Lymph vessels are present throughout the body and convey fluid from the extracellular space to eventually return the fluid to the vascular system. The walls of lymph capillaries are permeable and allow for the passage of relatively large substances such as cells and bacterial antigens into the lymphatic flow. As the lymph passes through lymph nodes, monitoring cells are able to detect antigens and initiate immune responses.
Lymph nodes are aggregates of lymphocytes organized in a reticular network consisting of reticular cells and reticular fibers enclosed by a dense connective tissue capsule. From the capsule connective tissue trabeculae penetrate into the organ. The lymph nodes receive lymph fluid through afferent lymph vessels. The lymph then passes through subcapsular sinuses, trabecular sinuses, medullary sinuses to eventually exit through an efferent lymph vessel. The sinuses within the lymph node are not open vascular spaces, instead cellular processes from surrounding macrophages and reticular cells intersect them, hampering flow through the node and enhancing filtration of lymph fluid and antigen detection. The sinuses are visible as white spaces within the lymph node.
Underlying the capsule is a darkly stained region termed the cortex, the center of the lymph node is termed the medulla, and stains lighter. The cortex is divided into a superficial and a deep cortex. Within the superficial cortex multiple spherical aggregations of lymphocytes are present. Aggregations of only small, dark lymphocytes are termed primary follicles. If the central region contains larger, paler cells they are termed secondary follicles. Secondary follicles are formed when a lymphocyte that has recognized its antigen returns to a primary follicle and starts proliferating, to form a germinal center. The less dark staining of immature B-cells is due to the less densely packed euchromatin in the corresponding cell nuclei. Lymph follicles are absent in the deep cortex, which is composed mainly of T-cells.
Cancer: Lymphoma
|